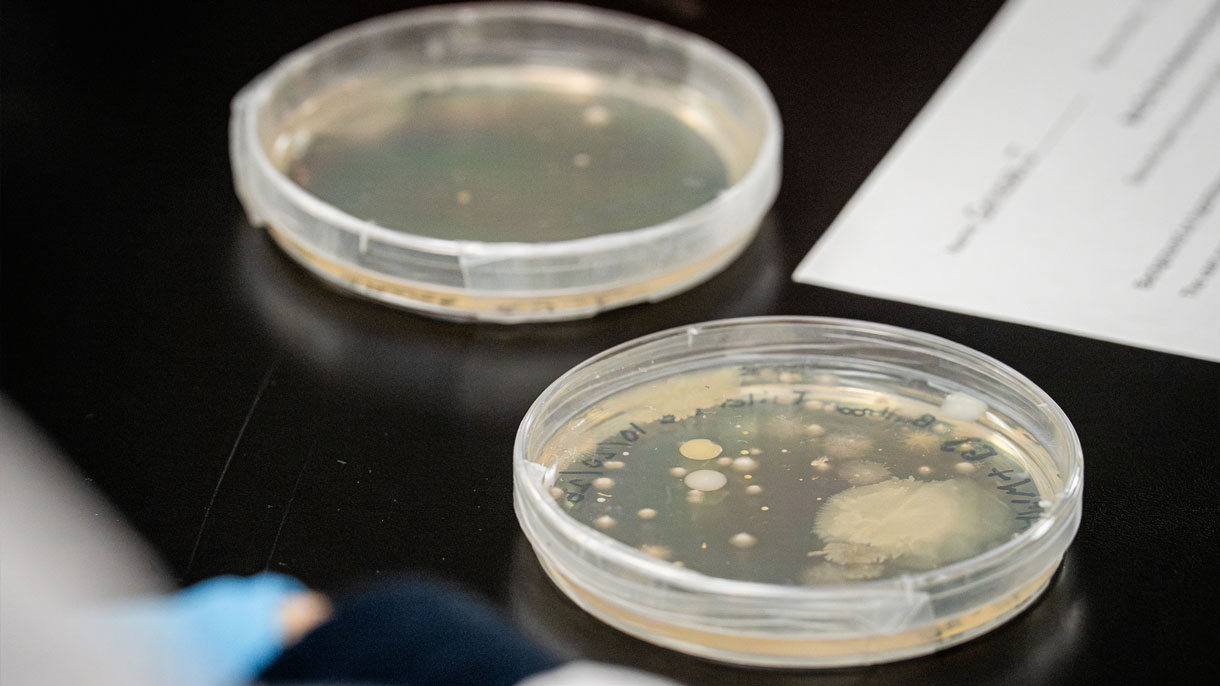
Petri dishes

Pre-Fall Programs
Pre-Fall Programs allow you to get an early start on making connections with the Sacred Heart community and classmates who share your interests!
During this active and fun-filled week, upper-level student-leaders in each program will help as you make new friends, get to know SHU administrators and faculty outside the classroom, meet staff and learn more about SHU before the semester begins!
Pre-fall participants arrive on campus early and ease into their first year at Sacred Heart. Whatever your interests, Sacred Heart offers a program that is right for you. From healthy living strategies to service immersion, major exploration and student success, you can explore some of the exciting aspects of Sacred Heart and our surrounding communities.
Pre-fall move-in will take place on Saturday, August 22, and your pre-fall week will conclude on Thursday, August 27, right before Welcome Weekend.
We challenge you to take this opportunity to meet new people and acquire new skills!
Class of 2030 Pre-Fall Programs
- A Week of Wellness | College of Health Professions
- Behind the Curtain | Performing Arts: Theatre Arts Program
- Bio Pioneers | Biology
-
Community Connections | Community Engagement
- Dance Intensive | Performing Arts: Dance Program
- Mind Your Business | Welch College of Business & Technology
- Nursing, The Heart of Healthcare | Davis & Henley College of Nursing
- Raise Your Voice | Performing Arts: Choral Program
- Sports Media | Communication & Media
- Start Strong | Student Advising & Success




Pre-Fall Programs

Sports Media Pre-Fall student gaining hands-on experience behind the camera

Sports Media Pre-Fall student gaining experience being in front of the camera

Sports Media Pre-Fall students visit NBC Sports

Start Strong Pre-fall students get superlatives at the end of the program

Start Strong Pre-Fall students make slime together

Start Strong Pre-Fall students visit the rock wall in the Valentine Health & Recreation Center

A Week of Wellness students pose for a group photo

A Week of Wellness students in the simulation lab

A Week of Wellness students getting hands on experience in the simulation lab

Behind the Curtain Pre-Fall students pose for a group photo

Behind the Curtain Pre-Fall students travel to NYC to see a Broadway show

Behind the Curtain Pre-Fall students travel to NYC to see “Maybe Happy Ending” on Broadway
Bio Pioneers Pre-Fall students gaining hands on laboratory experience

Bio Pioneers Pre-Fall students learning from our staff

Bio Pioneers Pre-Fall students in the classroom

Community Connections students giving back to the community

Community Connections students pose for a group photo in front of the chapel

Dance Intensive Pre-Fall students performing one of their routines

Dance Intensive Pre-Fall students performing on the Edgerton stage

Dance Intensive Claddagh dancers on the Pioneer Village Upper Quad

Mind Your Business students visit Total Mortgage Arena in Bridgeport

Mind your Business students dress in business casual

Mind Your Business students at West Campus

Pre-Fall Nursing students gaining hands on experience at the Center for Healthcare Education

Nursing Pre-Fall students helping in the community

Nursing Pre-Fall students gaining hands-on experience in the lab

Raise Your Voice students performing on the Edgerton stage
Sacred Heart University's pre-fall program was an unforgettable experience that kicked off my freshman year. I loved getting extra time on campus before classes started, but my favorite memories were made in the studios, where I spent time with amazing choreographers, teachers and friends. Not only did pre-fall bring me closer to the dance community at Sacred Heart, but it also gave me the confidence to start my first semester of college.
